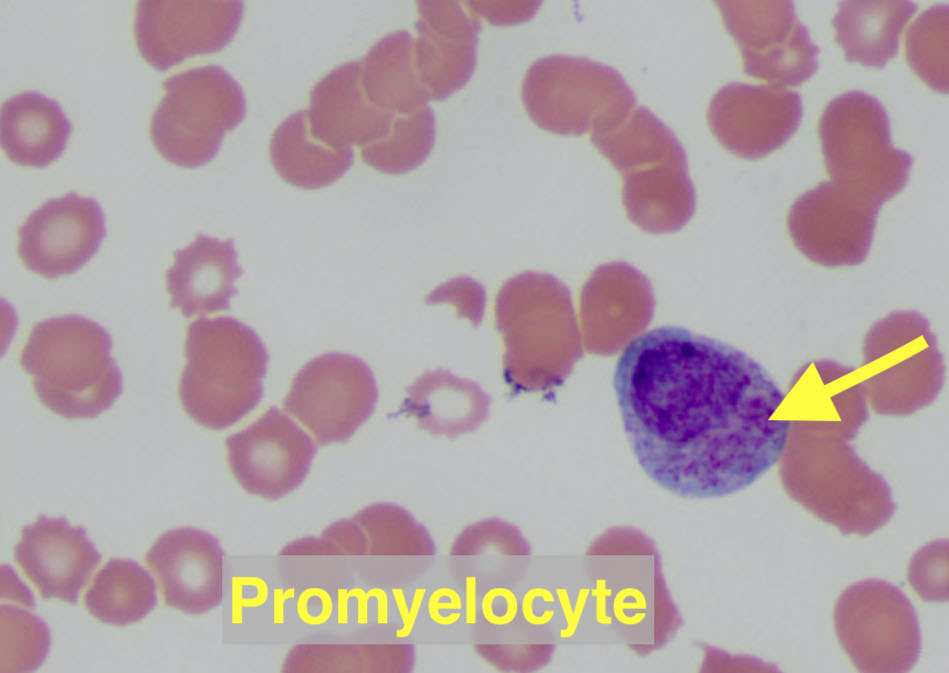
4/You checked for complications, stabilized the pt & sent flow cytometry. Now off to the lab!There you see: Many blasts (large nucleus, immature chromatin, scant cytoplasm) Few promyelocytes (light blue cytoplasm & magenta-staining granules)
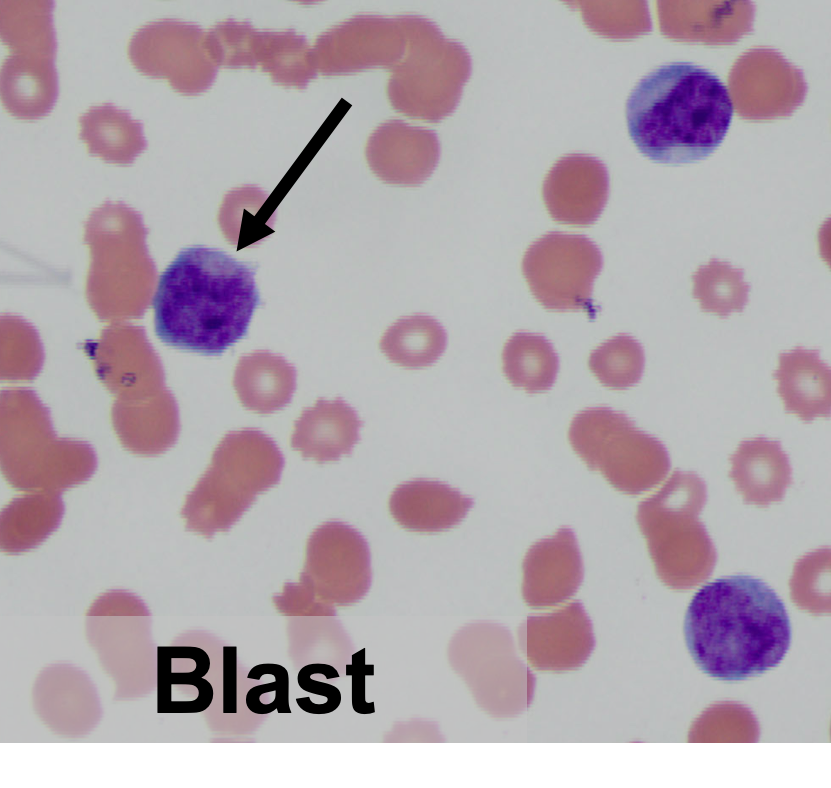
4/You checked for complications, stabilized the pt & sent flow cytometry. Now off to the lab!There you see: Many blasts (large nucleus, immature chromatin, scant cytoplasm) Few promyelocytes (light blue cytoplasm & magenta-staining granules)

1/
@HawraAllawati (senior resident) here! Current fellow/MGH res alum @the_tjroberts & I found ourselves checking off an infamous task at 2 AM
[x]swing special slide

This inspired the following ! Follow along & we guarantee that you will have a BLAST
! Follow along & we guarantee that you will have a BLAST  ! #MedTwitter
! #MedTwitter
@HawraAllawati (senior resident) here! Current fellow/MGH res alum @the_tjroberts & I found ourselves checking off an infamous task at 2 AM
[x]swing special slide


This inspired the following
 ! Follow along & we guarantee that you will have a BLAST
! Follow along & we guarantee that you will have a BLAST  ! #MedTwitter
! #MedTwitter
2/
63 M presents w CC of SOB x3 weeks. ROS: easy bruising.
T 39.0, BP130/80, O2 99% on 2L NC.
WBC 23K (2% neutrophils, 60% blasts), Hgb 8, plt 20. K 4, Cr 1.2, INR 1.7, D-dimer >1K, fibrinogen 112.
You pause and astutely start worrying about... acute leukemia!
What now?!
63 M presents w CC of SOB x3 weeks. ROS: easy bruising.
T 39.0, BP130/80, O2 99% on 2L NC.
WBC 23K (2% neutrophils, 60% blasts), Hgb 8, plt 20. K 4, Cr 1.2, INR 1.7, D-dimer >1K, fibrinogen 112.
You pause and astutely start worrying about... acute leukemia!
What now?!
3/
1)take a deep breath!
2)never worry alone! This IS something to your friendly onc fellow for (yes, even at 2 AM)! While you wait for a callback, you:
your friendly onc fellow for (yes, even at 2 AM)! While you wait for a callback, you:
3)Look for & treat dangerous complications of acute leukemia:
 Bleeding/DIC
Bleeding/DIC
 TLS
TLS
 Febrile Neutropenia
Febrile Neutropenia
 Leukostasis
Leukostasis
1)take a deep breath!
2)never worry alone! This IS something to
 your friendly onc fellow for (yes, even at 2 AM)! While you wait for a callback, you:
your friendly onc fellow for (yes, even at 2 AM)! While you wait for a callback, you:3)Look for & treat dangerous complications of acute leukemia:
 Bleeding/DIC
Bleeding/DIC TLS
TLS Febrile Neutropenia
Febrile Neutropenia Leukostasis
Leukostasis
4/
You checked for complications, stabilized the pt & sent flow cytometry.
 Now off to the lab!
Now off to the lab!
There you see:
 Many blasts (large nucleus, immature chromatin, scant cytoplasm)
Many blasts (large nucleus, immature chromatin, scant cytoplasm)
 Few promyelocytes (light blue cytoplasm & magenta-staining granules)
Few promyelocytes (light blue cytoplasm & magenta-staining granules)
You checked for complications, stabilized the pt & sent flow cytometry.
 Now off to the lab!
Now off to the lab!There you see:
 Many blasts (large nucleus, immature chromatin, scant cytoplasm)
Many blasts (large nucleus, immature chromatin, scant cytoplasm) Few promyelocytes (light blue cytoplasm & magenta-staining granules)
Few promyelocytes (light blue cytoplasm & magenta-staining granules)
5/
What do you -with the help of an onc fellow- do FIRST?
Flow= flow cytometry
ATRA= All trans-retinoic acid
BM= Bone marrow
What do you -with the help of an onc fellow- do FIRST?
Flow= flow cytometry
ATRA= All trans-retinoic acid
BM= Bone marrow
6/
Before we answer, let's review your suspected Dx, APL!
 Epi: 8% of adult AML cases. Median age 47
Epi: 8% of adult AML cases. Median age 47
 can present w pancytopenia & associated sx (fatigue, SOB, bleed/bruise). Leukocytosis (like in this case) is a marker of high-risk disease https://www.ncbi.nlm.nih.gov/books/NBK459352/
can present w pancytopenia & associated sx (fatigue, SOB, bleed/bruise). Leukocytosis (like in this case) is a marker of high-risk disease https://www.ncbi.nlm.nih.gov/books/NBK459352/
Before we answer, let's review your suspected Dx, APL!
 Epi: 8% of adult AML cases. Median age 47
Epi: 8% of adult AML cases. Median age 47 can present w pancytopenia & associated sx (fatigue, SOB, bleed/bruise). Leukocytosis (like in this case) is a marker of high-risk disease https://www.ncbi.nlm.nih.gov/books/NBK459352/
can present w pancytopenia & associated sx (fatigue, SOB, bleed/bruise). Leukocytosis (like in this case) is a marker of high-risk disease https://www.ncbi.nlm.nih.gov/books/NBK459352/
7/
 Dx: t(15,17) translocation (that results in fusion of PML-RAR gene). You don't need 20% blasts if that's present
Dx: t(15,17) translocation (that results in fusion of PML-RAR gene). You don't need 20% blasts if that's present
Pathophys: PML-RARA fusion protein blocks differentiation cells are stuck in the promyelocyte stage
cells are stuck in the promyelocyte stage
 Dx: t(15,17) translocation (that results in fusion of PML-RAR gene). You don't need 20% blasts if that's present
Dx: t(15,17) translocation (that results in fusion of PML-RAR gene). You don't need 20% blasts if that's presentPathophys: PML-RARA fusion protein blocks differentiation
 cells are stuck in the promyelocyte stage
cells are stuck in the promyelocyte stage
8/
 Prognosis: w/o tx, short term survival is very poor! Median survival is <1 mo.
Prognosis: w/o tx, short term survival is very poor! Median survival is <1 mo.

 A major cause of this is hemorrhage! Up to 40% can have a fatal head bleed
A major cause of this is hemorrhage! Up to 40% can have a fatal head bleed
 That's why coagulopathy & APL = medical emergency!
That's why coagulopathy & APL = medical emergency!
But why are pts with APL so prone to bleeding?
 Prognosis: w/o tx, short term survival is very poor! Median survival is <1 mo.
Prognosis: w/o tx, short term survival is very poor! Median survival is <1 mo. 
 A major cause of this is hemorrhage! Up to 40% can have a fatal head bleed
A major cause of this is hemorrhage! Up to 40% can have a fatal head bleed That's why coagulopathy & APL = medical emergency!
That's why coagulopathy & APL = medical emergency! But why are pts with APL so prone to bleeding?
9/
Simplified into 2 main mechanisms:
 DIC
DIC
(unlike in sepsis there are higher levels of Protein C&S in APL hence bleeding)
bleeding)
 Hyperfibrinolysis
Hyperfibrinolysis
Annexin II (expressed on blasts) plasmin by tPA dependent mechanism
plasmin by tPA dependent mechanism  fibrinolysis.
fibrinolysis.
More on this: https://pubmed.ncbi.nlm.nih.gov/29703489/
Simplified into 2 main mechanisms:
 DIC
DIC (unlike in sepsis there are higher levels of Protein C&S in APL hence
 bleeding)
bleeding) Hyperfibrinolysis
HyperfibrinolysisAnnexin II (expressed on blasts)
 plasmin by tPA dependent mechanism
plasmin by tPA dependent mechanism  fibrinolysis.
fibrinolysis.More on this: https://pubmed.ncbi.nlm.nih.gov/29703489/
10/
Therefore w acute leukemia (& esp if APL is suspected):
 Do a neuro exam (
Do a neuro exam ( head bleed in APL)
head bleed in APL)
 Check Plt, D-dimer, fibrinogen, INR & have a low transfusion threshold: Fibrinogen >150, plt >30-50,INR <1.5
Check Plt, D-dimer, fibrinogen, INR & have a low transfusion threshold: Fibrinogen >150, plt >30-50,INR <1.5
 ATRA as soon as you *SUSPECT* APL (don't need confirmed dx)
ATRA as soon as you *SUSPECT* APL (don't need confirmed dx)
Therefore w acute leukemia (& esp if APL is suspected):
 Do a neuro exam (
Do a neuro exam ( head bleed in APL)
head bleed in APL) Check Plt, D-dimer, fibrinogen, INR & have a low transfusion threshold: Fibrinogen >150, plt >30-50,INR <1.5
Check Plt, D-dimer, fibrinogen, INR & have a low transfusion threshold: Fibrinogen >150, plt >30-50,INR <1.5 ATRA as soon as you *SUSPECT* APL (don't need confirmed dx)
ATRA as soon as you *SUSPECT* APL (don't need confirmed dx)
11/
 ATRA promotes the terminal differentiation of malignant immature promyelocytes to mature neutrophils!
ATRA promotes the terminal differentiation of malignant immature promyelocytes to mature neutrophils!
 Despite high early mortality, with treatment, remission rates can be >90% !!
Despite high early mortality, with treatment, remission rates can be >90% !!
Back to the case:
You treated the pt w ATRA, transfused & later confirmed the dx of APL!
 ATRA promotes the terminal differentiation of malignant immature promyelocytes to mature neutrophils!
ATRA promotes the terminal differentiation of malignant immature promyelocytes to mature neutrophils!  Despite high early mortality, with treatment, remission rates can be >90% !!
Despite high early mortality, with treatment, remission rates can be >90% !!Back to the case:
You treated the pt w ATRA, transfused & later confirmed the dx of APL!
12/
Take home points:
 Acute leukemia? Look for DIC/bleeding, TLS, febrile neutropenia, leukostasis
Acute leukemia? Look for DIC/bleeding, TLS, febrile neutropenia, leukostasis
 Pts. with APL have high short term mortality & high risk of bleeding. Make sure you check coags & do a neuro exam
Pts. with APL have high short term mortality & high risk of bleeding. Make sure you check coags & do a neuro exam
 Start ATRA if you suspect APL!
Start ATRA if you suspect APL!
Take home points:
 Acute leukemia? Look for DIC/bleeding, TLS, febrile neutropenia, leukostasis
Acute leukemia? Look for DIC/bleeding, TLS, febrile neutropenia, leukostasis Pts. with APL have high short term mortality & high risk of bleeding. Make sure you check coags & do a neuro exam
Pts. with APL have high short term mortality & high risk of bleeding. Make sure you check coags & do a neuro exam Start ATRA if you suspect APL!
Start ATRA if you suspect APL!
13/ Thank you for following along this #tweetorial Feedback is welcome!
*case details were changed to protect pt privacy*
S/o to chief @ArielleMedford for reviewing this with me!
*case details were changed to protect pt privacy*
S/o to chief @ArielleMedford for reviewing this with me!

 Read on Twitter
Read on Twitter![1/ @HawraAllawati (senior resident) here! Current fellow/MGH res alum @the_tjroberts & I found ourselves checking off an infamous task at 2 AM[x]swing special slideThis inspired the following ! Follow along & we guarantee that you will have a BLAST ! #MedTwitter 1/ @HawraAllawati (senior resident) here! Current fellow/MGH res alum @the_tjroberts & I found ourselves checking off an infamous task at 2 AM[x]swing special slideThis inspired the following ! Follow along & we guarantee that you will have a BLAST ! #MedTwitter](https://pbs.twimg.com/media/EdDVyFKXkAEM5Vn.jpg)